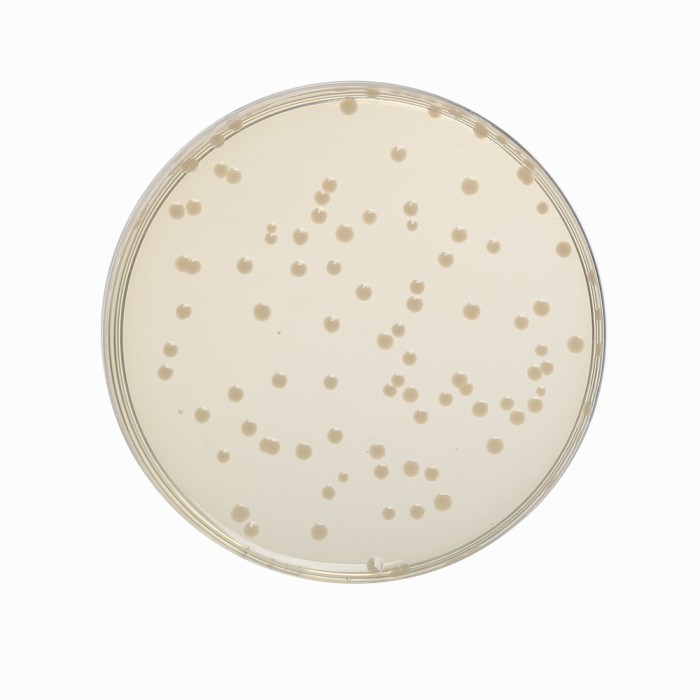
Nutrient Agar No.2, Granulated

Your enquiry has been submitted
Nutrient Agar, Granulated
Intended use
A general purpose medium used for the cultivation of less fastidious microorganisms and can be enriched with blood or other biological fluids.
Composition**
| Ingredients | g/L |
|---|---|
| Peptone | 5.000 |
| Sodium chloride | 5.000 |
| HM peptone B# | 1.500 |
| Yeast extract | 1.500 |
| Agar | 15.000 |
| Final pH (at 25°C) | 7.4±0.2 |
**Formula adjusted, standardized to suit performance parameters
# - Equivalent to Beef extract
Directions
Suspend 28.0 grams in 1000 ml purified / distilled water. Heat to boiling to dissolve the medium completely. Sterilize by autoclaving at 15 lbs pressure (121°C) for 15 minutes. Cool to 45-50°C. If desired, the medium can be enriched with 5-10% blood or other biological fluids. Mix well and pour into sterile Petri plates.
Principle And Interpretation
Nutrient media are basic culture media used for maintaining microorganisms, cultivating fastidious organisms by enriching with serum or blood and are also used for purity checking prior to biochemical or serological testing (1,2). Nutrient Agar is ideal for demonstration and teaching purposes where a more prolonged survival of cultures at ambient temperature is often required without risk of overgrowth that can occur with more nutritious substrate. This relatively simple formula has been retained and is still widely used in the microbiological examination of variety of materials and is also recommended by standard methods. It is one of the several non-selective media useful in routine cultivation of microorganisms (3,4). It can be used for the cultivation and enumeration of bacteria which are not particularly fastidious. Addition of different biological fluids such as horse or sheep blood, serum, egg yolk etc. makes it suitable for the cultivation of related fastidious organisms. Peptone, HM peptone B and yeast extract provide the necessary nitrogen compounds, carbon, vitamins and also some trace ingredients necessary for the growth of bacteria. Sodium chloride maintains the osmotic equilibrium of the medium.
Type of specimen
Clinical samples - faeces, urine, etc; Food and dairy samples; Water samples
Specimen Collection and Handling:
For clinical samples follow appropriate techniques for handling specimens as per established guidelines (5,6).
For food and dairy samples, follow appropriate techniques for sample collection and processing as per guidelines (3,4,7).
For water samples, follow appropriate techniques for sample collection, processing as per guidelines and local standards.(8)
After use, contaminated materials must be sterilized by autoclaving before discarding.
Warning and Precautions :
In Vitro diagnostic use. For professional use only. Read the label before opening the container. Wear protective gloves/protective clothing/eye protection/ face protection. Follow good microbiological lab practices while handling specimens and culture. Standard precautions as per established guidelines should be followed while handling clinical specimens. Safety guidelines may be referred in individual safety data sheets.
Limitations :
- Individual organisms differ in their growth requirement and may show variable growth patterns on the medium.
- Each lot of the medium has been tested for the organisms specified on the COA. It is recommended to users to validate the medium for any specific microorganism other than mentioned in the COA based on the user's unique requirement.
Performance and Evaluation
Performance of the medium is expected when used as per the direction on the label within the expiry period when stored at recommended temperature.
Quality Control
Appearance
Cream to yellow homogenous granular media.
Gelling
Firm, comparable with 1.5% Agar gel
Colour and Clarity of prepared medium
Light yellow coloured clear to slightly opalescent gel forms in Petri plates
Reaction
Reaction of 2.8% w/v aqueous solution at 25°C. pH: 7.4±0.2
pH
7.20-7.60
Cultural Response
Productivity: Cultural characteristics observed after an incubation at 35-37°C for 18-48 hours.
| Organism | Inoculum (CFU) | Growth | Recovery |
|---|---|---|---|
| Escherichia coli ATCC 25922 (00013*) | 50-100 | good-luxuriant | >=70% |
| Pseudomonas aeruginosa ATCC 27853 (00025*) | 50-100 | good-luxuriant | >=70% |
| Salmonella Typhi ATCC 6539 | 50-100 | good-luxuriant | >=70% |
| Staphylococcus aureus subsp. aureus ATCC 25923 (00034*) | 50-100 | good-luxuriant | >=70% |
| Streptococcus pyogenes ATCC 19615 | 50-100 | good-luxuriant | >=70% |
| Salmonella Enteritidis ATCC 13076 (00030*) | 50-100 | good-luxuriant | >=70% |
| Salmonella Typhimurium ATCC 14028 (00031*) | 50-100 | good-luxuriant | >=70% |
| Yersinia enterocolitica ATCC 9610 (00038*) | 50-100 | good-luxuriant | >=70% |
| Yersinia enterocolitica ATCC 23715 (00160*) | 50-100 | good-luxuriant | >=70% |
Key : *Corresponding WDCM numbers.
Storage and Shelf Life
Store between 10-30°C in a tightly closed container and the prepared medium at 20-30°C. Use before expiry date on the label. On opening, product should be properly stored dry, after tightly capping the bottle in order to prevent lump formation due to the hygroscopic nature of the product. Improper storage of the product may lead to lump formation. Store in dry ventilated area protected from extremes of temperature and sources of ignition Seal the container tightly after use. Product performance is best if used within stated expiry period.
Disposal
User must ensure safe disposal by autoclaving and/or incineration of used or unusable preparations of this product. Follow established laboratory procedures in disposing of infectious materials and material that comes into contact with clinical sample must be decontaminated and disposed of in accordance with current laboratory techniques (5,6).
Reference
- Lapage S., Shelton J. and Mitchell T., 1970, Methods in Microbiology', Norris J. and Ribbons D., (Eds.), Vol. 3A, Academic Press, London.
- MacFaddin J. F., 2000, Biochemical Tests for Identification of Medical Bacteria, 3rd Ed., Lippincott, Williams and Wilkins, Baltimore.
| Product Name | Nutrient Agar, Granulated |
|---|---|
| SKU | GM001 |
| Application/ Industry | General Purpose |
| Product Type | Granulated |
| Physical Form | Granular |
| Regulatory | APHA |
| Origin | Animal |
| Packaging type | HDPE |
| References | 1. American Public Health Association, Standard Methods for the Examination of Dairy Products, 1978, 14th Ed., WashingtonD.C. 2.Salfinger Y., and Tortorello M.L. Fifth (Ed.), 2015, Compendium of Methods for the Microbiological Examination ofFoods, 5th Ed., American Public Health Association, Washington, D.C. 3.Baird R.B., Eaton A.D., and Rice E.W., (Eds.), 2015, Standard Methods for the Examination of Water andWastewater, 23rd ed., APHA, Washington, D.C. 4.Isenberg, H.D. Clinical Microbiology Procedures Handbook. 2nd Edition. 5.Jorgensen,J.H., Pfaller , M.A., Carroll, K.C., Funke, G., Landry, M.L., Richter, S.S and Warnock., D.W. (2015)Manual of Clinical Microbiology, 11th Edition. Vol. 1. 6.Lapage S., Shelton J. and Mitchell T., 1970, Methods in Microbiology, Norris J. and Ribbons D., (Eds.), Vol. 3A,Academic Press, London. 7.MacFaddin J. F., 2000, Biochemical Tests for Identification of Medical Bacteria, 3rd Ed., Lippincott, Williams and Wilkins,Baltimore. 8.Wehr H. M. and Frank J. H., 2004, Standard Methods for the Microbiological Examination of Dairy Products, 17th Ed.,APHA Inc., Washington, D.C. |